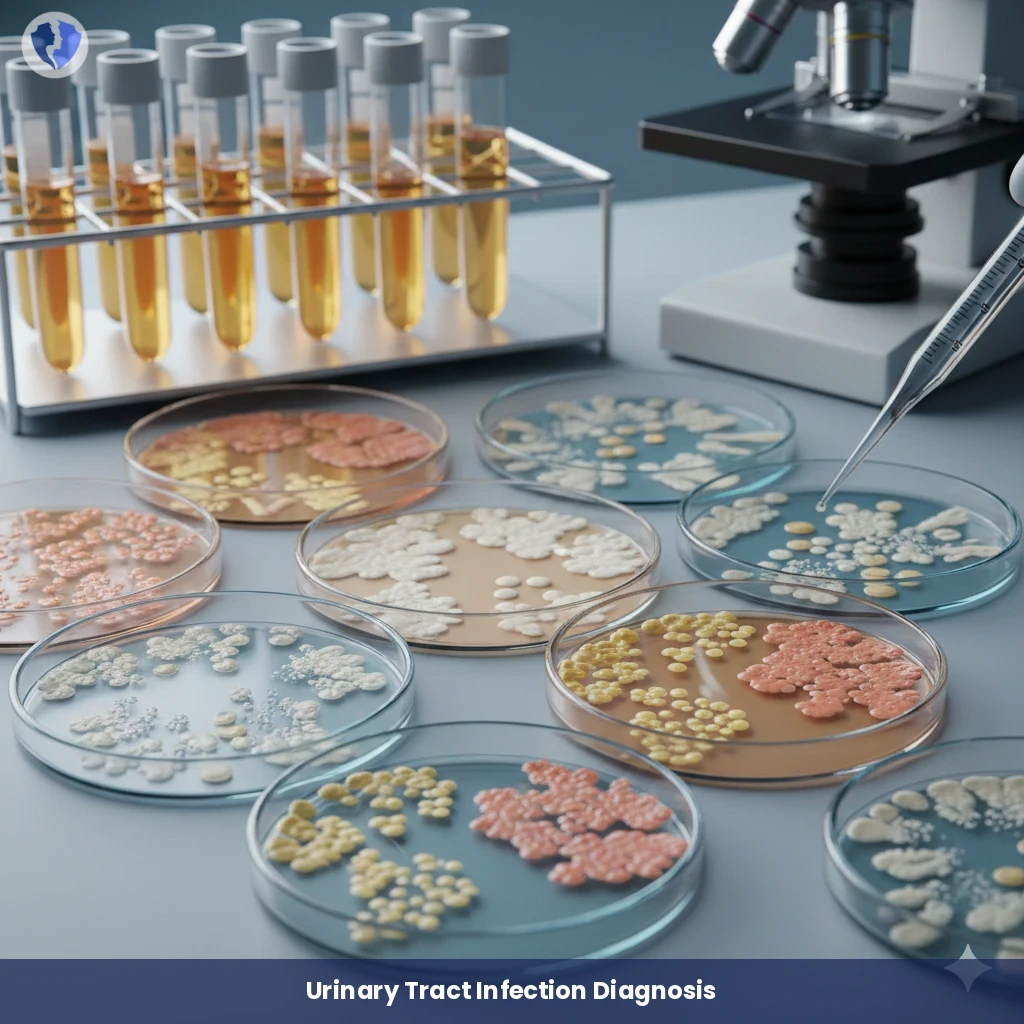
Urine Culture and Sensitivity

Service Details
Urine Culture and Sensitivity
A standard microbiological examination is considered the gold standard for diagnosing urinary tract infections (UTIs). A known volume of urine is cultured on special nutrient media that allow the growth of the bacteria present. After incubation, the bacterial colonies are counted to determine if the number is clinically significant (usually ≥ 10⁵ colony-forming units/mL). If the growth is significant, the type of bacteria is identified, and then an antibiotic susceptibility test (antibiogram) is performed to determine which antibiotics the bacteria are sensitive or resistant to.